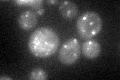
YHL002W
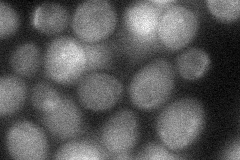
YHL002W
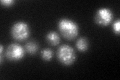
YHL002W
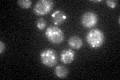
YHL002W

View description
Subunit of the endosomal Vps27p-Hse1p complex required for sorting of ubiquitinated membrane proteins into intralumenal vesicles prior to vacuolar degradation, as well as for recycling of Golgi proteins and formation of lumenal membranes
Localization:
Intensity:
Fold change:
Significance:
-
C’ GFP library in SD
punctate34.43 -
N' NOP1pr-GFP in SD

cytosol,punctate69.3404 -
N' TEF2pr-mCherry in SD

cytosol,punctate51.2228 -
N' NATIVEpr-GFP in SD

punctate32.3882 -
N' TEF2pr-VC and Cyto-VN in SD
cytosol34.4043 -
C’ GFP library in SD+DTT
punctate52.131.51Yes -
C’ GFP library in SD+H2O2

punctate39.261.14No -
C’ GFP library in Starvation Media
punctate53.61.55Yes -
C’ GFP library on the background of Pup2-DaMP

punctate -
C’ GFP library on the background of CCT mutant

punctate37.55591.09057No
